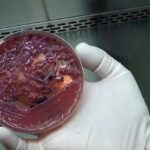
Superbactéria é Identificada Em 7 Pacientes E Leva Ao Fechamento De Uti

Superbactéria é identificada em 7 pacientes e leva ao fechamento de UTI

Por conta da identificação de sete pessoas internadas com a bactéria multirresistente KPC, a UTI Adulto do Hospital Municipal Dr. Mário Gatti, em Campinas (SP), foi fechada temporariamente e não receberá novos pacientes a partir desta terça-feira (10).
Segundo a prefeitura, a presença da bactéria foi detectada durante o monitoramento de rotina feito pelas equipes assistenciais e pela Comissão de Controle de Infecção Hospitalar. A KPC é um tipo de bactéria resistente a vários antibióticos e pode circular em ambientes hospitalares de alta complexidade, de acordo com a administração.
Em entrevista à EPTV, Andrea Von Zuben, coordenadora do setor de informações da Rede Mário Gatti, explicou que a bactéria é considerada comum no ambiente hospitalar e que é manejada com protocolos já conhecidos. No entanto, neste episódio, a UTI precisou ser fechada para novos pacientes devido à dificuldade de contenção dos casos.
A partir da suspensão temporária, quem precisar de leito de UTI será direcionado para o Hospital Ouro Verde ou para outras unidades, por meio da central de regulação municipal. Tanto a central quanto o Samu já foram orientados a não enviar novos pacientes ao Mário Gatti enquanto durar a restrição.
Medidas de Contingência
Para conter o surto, a Prefeitura de Campinas informou que isolou os sete pacientes infectados em um salão específico da UTI, com equipe exclusiva para atendimento.
Outros três pacientes que estavam internados na mesma ala serão transferidos para leitos de igual complexidade em outras unidades da rede municipal. Também haverá reforço na limpeza e na desinfecção do espaço.
Ainda de acordo com a administração municipal, o plano de contingência foi enviado ainda na manhã desta segunda-feira (9) ao Departamento de Vigilância em Saúde (Devisa) e está em análise.

Entre em Contato
Entre em Contato